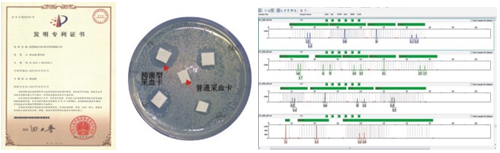

Introduction:
DNA storage card(DNA blood sample card) is a new medium based on vegetable fibre for DNA storage, particularly for collection, transportation and storage of different kinds of biological fluid(e.g. Blood, semen, saliva), cell culture fluid, microorganism, vegetable fibre, virus. By the distinct fomular and production engineering, this product obtains the ability of protein denaturation, cytomembrane burst, DNA adsorption and bacterialstat, and thus ensure the target DNA could be stored on the card for years without losing PCR efficacy. The safety of operation and transportation are also guaranteed since the denaturation of protein could also make pathogenic microorganism and virus lose the activity.
Characteristics:
1. Denature pathogenic microorganism and virus in the sample and avoid the contamination to the operators.
2. DNA sample could be stored under room temperature for long term, lower the cost for DNA storage.
3. Could be used for DNA sample transportation under room temperature.
4. One sample could be used for multi-purpose test with multi-times, convenient for re-examination
Application:
Collection, storage and transportation of DNA:
DNA storage cardcould be used for DNA extraction and PCR in the forensics and paternity test. It could be used for building a simple, eazy-operated DNA auto-extraction program by auto DNA extraction instruments. It could significantly lower the requiredamount for the blood sample, inactivate the infectious germ and virus, and avoid the contamination to the operator, especially for the blood collection from high risk population.